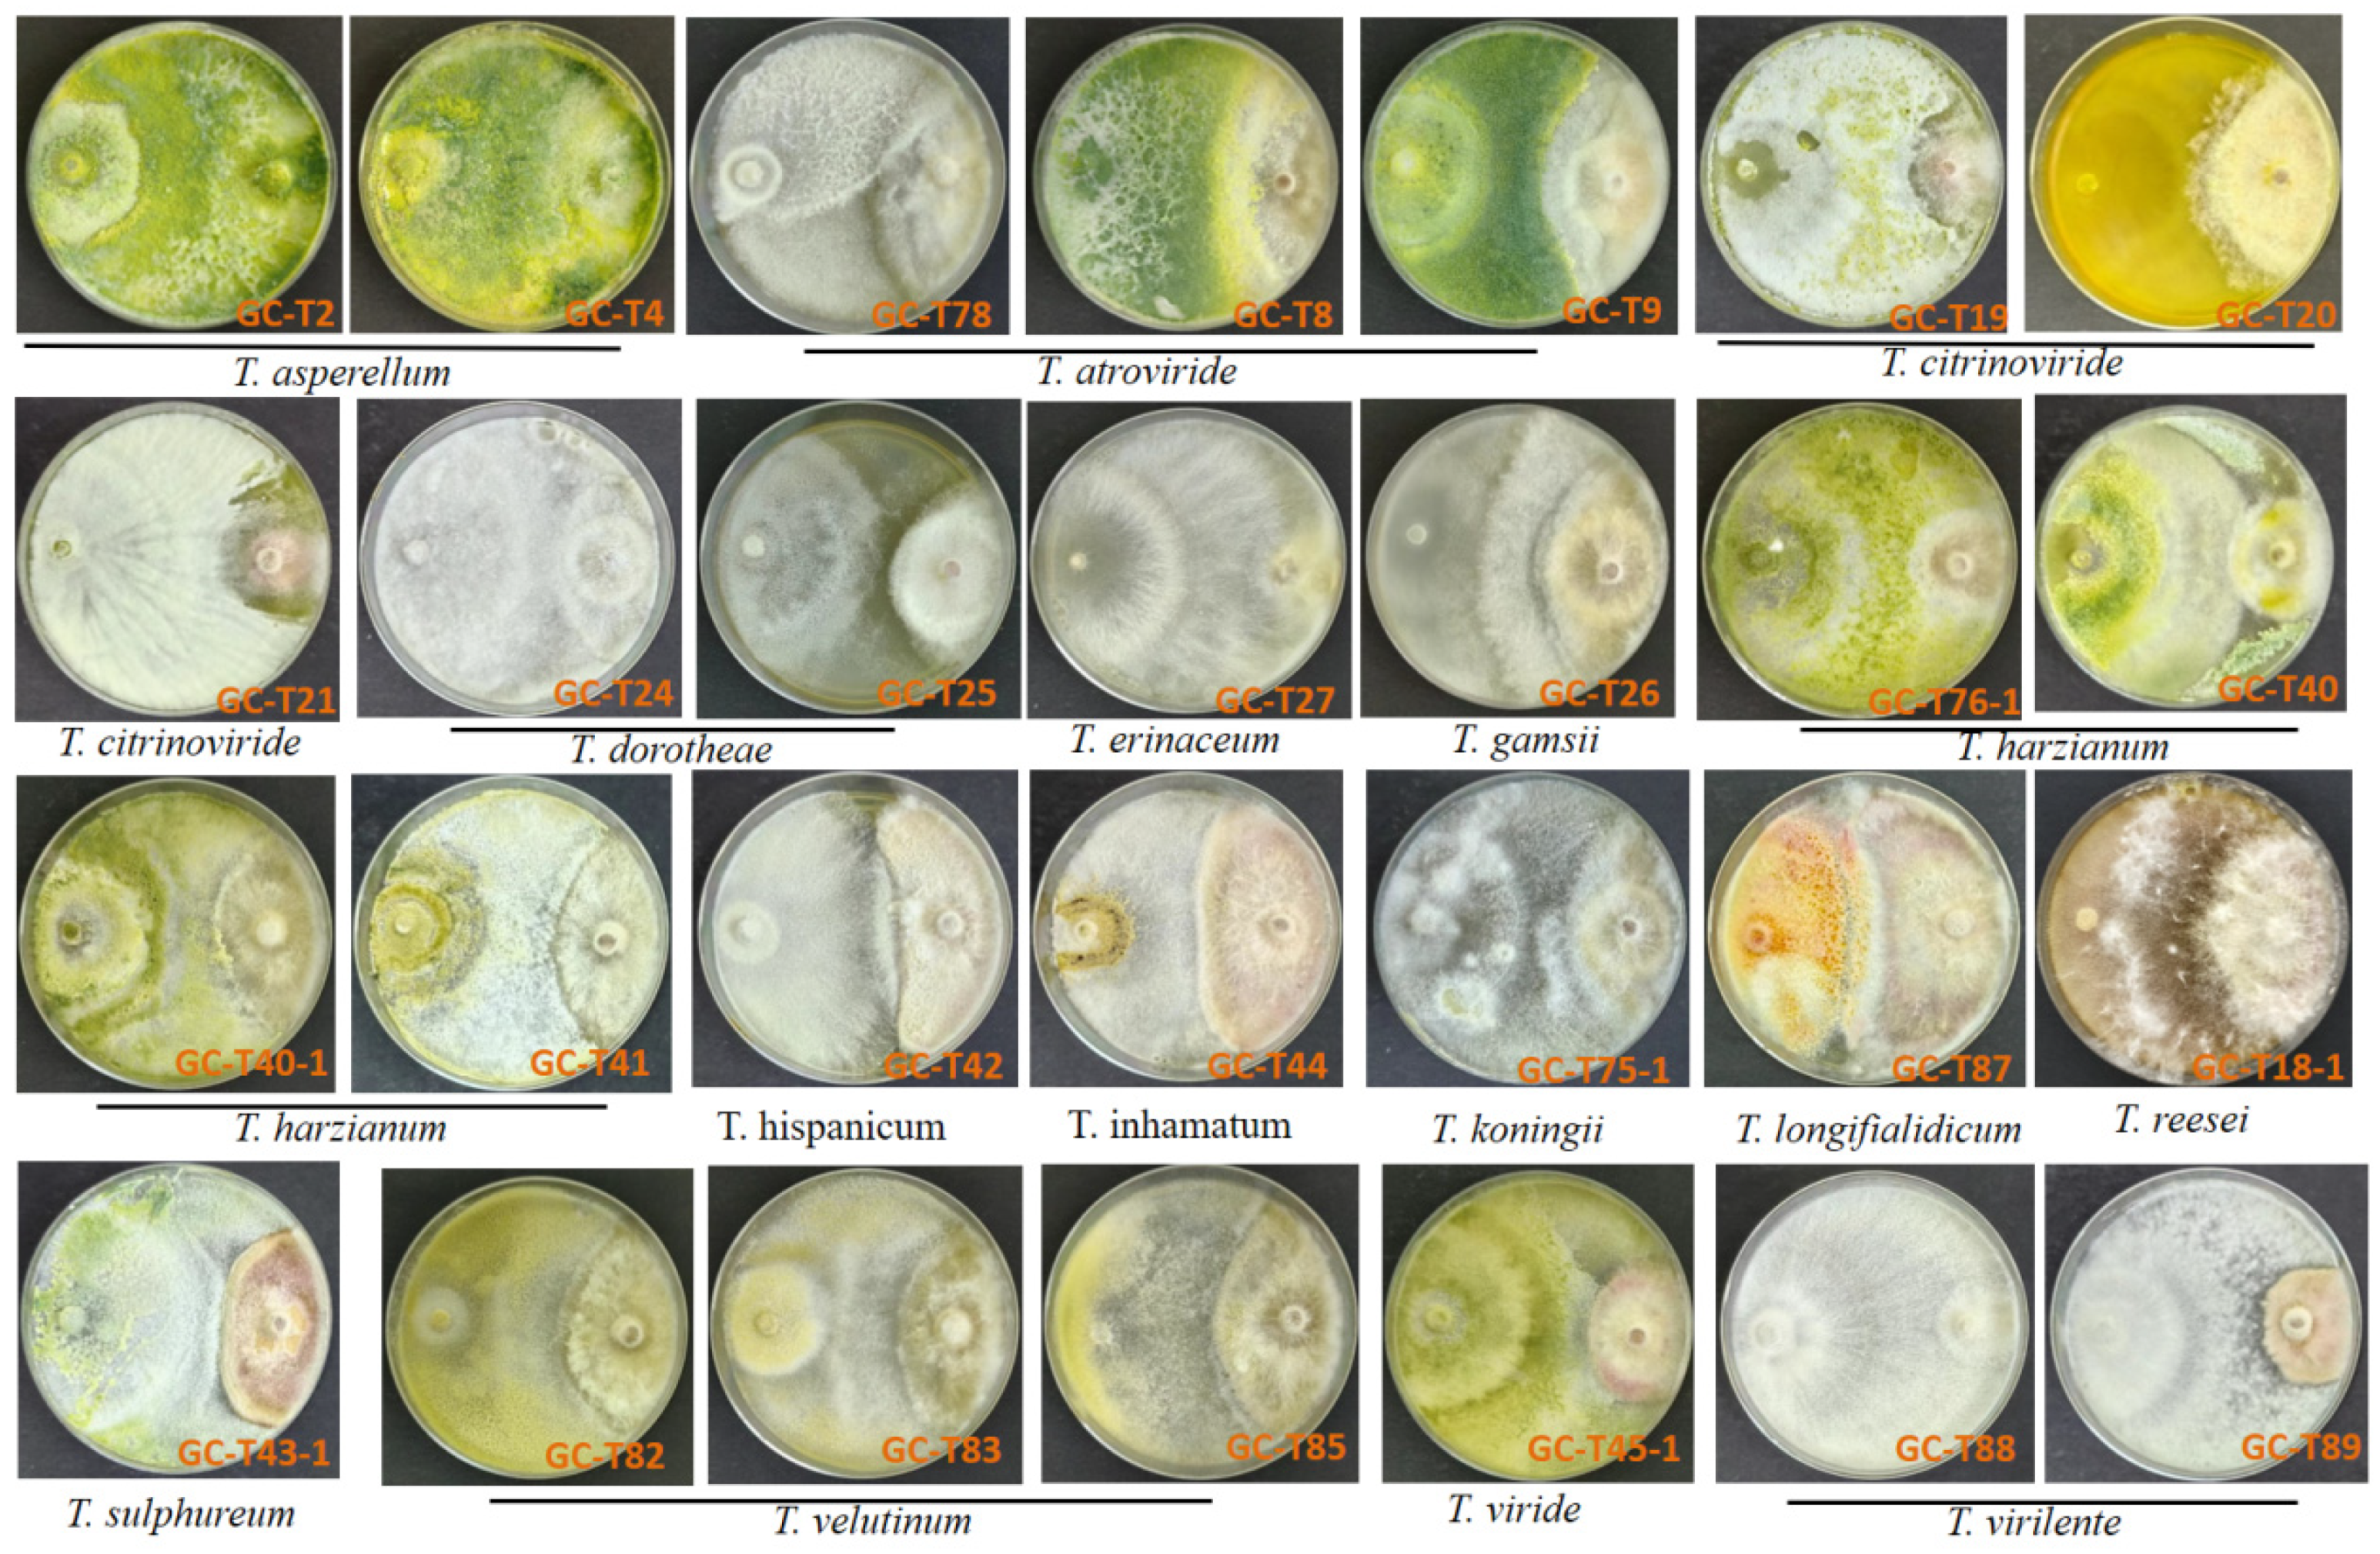
Jof 11 00521 g001

Interaction of Trichoderma Species with Fusarium graminearum Growth and Its Trichothecene Biosynthesis as Further Contribution in Selection of Potential Biocontrol Agents
Abstract
1. Introduction
2. Materials and Methods
2.1. Chemicals
2.2. Fungal Strains
2.3. Antagonism of Trichoderma spp. Against F. graminearum Growth and DON/3-ADON/15-ADON Production
2.4. Effect of Non-Volatiles of Trichoderma spp. on F. graminearum Growth and DON/3-ADON/15-ADON Production
2.5. Effect of Non-Volatiles of Trichoderma GC-T88 on the Expression of DON Biosynthesis Genes
2.6. Effect of Volatiles of Trichoderma spp. on F. graminearum Growth and DON/3-ADON/15-ADON Production
2.7. The Tolerance of Trichoderma spp. to the Toxicity of F. graminearum Metabolites
2.8. Potential of Trichoderma spp. to Produce DON/3-ADON/15-ADON
2.9. Determination of DON/3-ADON/15-ADON by UPLC-MS/MS
2.10. Statistical Analysis
3. Results
3.1. Interactions Between Trichoderma spp. and F. graminearum in Dual-Culture Assay
3.1.1. Trichoderma spp. Were Antagonistic Against F. graminearum Growth in Dual-Culture
3.1.2. Trichoderma spp. Inhibit DON/3-ADON/15-ADON Production by F. graminearum in Dual-Culture
3.2. Influence of Trichoderma Metabolites on F. graminearum
3.2.1. Trichoderma Non-Volatile Metabolites Inhibit F. graminearum Growth
3.2.2. Trichoderma Non-Volatile Metabolites Inhibit DON/3-ADON/15-ADON Production
3.2.3. Trichoderma Volatile Metabolites Inhibit F. graminearum Growth
3.2.4. Trichoderma Volatile Metabolites Inhibit DON/3-ADON/15-ADON Production by F. graminearum, While Volatiles of GC-T45-1 Act Oppositely
3.3. Interactions Between DON/3-ADON/15-ADON and Trichoderma
3.3.1. Trichoderma Tolerance to the Toxicity of F. graminearum PG-Fg1 Metabolites
3.3.2. Trichoderma spp. Have No Ability to Produce DON/3-ADON/15-ADON
4. Discussion
5. Conclusions
Supplementary Materials
Author Contributions
Funding
Data Availability Statement
Conflicts of Interest
References
- Edite Bezerra da Rocha, M.; Freire, F.d.C.O.; Erlan Feitosa Maia, F.; Izabel Florindo Guedes, M.; Rondina, D. Mycotoxins and their effects on human and animal health. Food Control 2014, 36, 159–165. [Google Scholar] [CrossRef]
- Alshannaq, A.; Yu, J.H. Occurrence, Toxicity, and Analysis of Major Mycotoxins in Food. Int. J. Environ. Res. Public Health 2017, 14, 632. [Google Scholar] [CrossRef] [PubMed]
- Geiser, D.M.; Al-Hatmi, A.M.S.; Aoki, T.; Arie, T.; Balmas, V.; Barnes, I.; Bergstrom, G.C.; Bhattacharyya, M.K.; Blomquist, C.L.; Bowden, R.L.; et al. Phylogenomic Analysis of a 55.1-kb 19-Gene Dataset Resolves a Monophyletic Fusarium that Includes the Fusarium solani Species Complex. Phytopathology 2021, 111, 1064–1079. [Google Scholar] [CrossRef]
- Dweba, C.C.; Figlan, S.; Shimelis, H.A.; Motaung, T.E.; Sydenham, S.; Mwadzingeni, L.; Tsilo, T.J. Fusarium head blight of wheat: Pathogenesis and control strategies. Crop Prot. 2017, 91, 114–122. [Google Scholar] [CrossRef]
- Wegulo, S.N.; Baenziger, P.S.; Hernandez Nopsa, J.; Bockus, W.W.; Hallen-Adams, H. Management of Fusarium head blight of wheat and barley. Crop Prot. 2015, 73, 100–107. [Google Scholar] [CrossRef]
- Dean, R.; Kan, J.A.L.V.; Pretorius, Z.A.; Hammond-Kosack, K.E.; Pietro, A.D.; Spanu, P.D.; Rudd, J.J.; Dickman, M.; Kahmann, R.; Ellis, J. The Top 10 fungal pathogens in molecular plant pathology. Mol. Plant Pathol. 2012, 13, 414–430. [Google Scholar] [CrossRef] [PubMed]
- Chen, Y.; Kistler, H.C.; Ma, Z. Fusarium graminearum Trichothecene Mycotoxins: Biosynthesis, Regulation, and Management. Annu. Rev. Phytopathol. 2019, 57, 15–39. [Google Scholar] [CrossRef]
- Munkvold, G.P.; Proctor, R.H.; Moretti, A. Mycotoxin Production in Fusarium According to Contemporary Species Concepts. Annu. Rev. Phytopathol. 2021, 59, 373–402. [Google Scholar] [CrossRef]
- Kelly, A.C.; Clear, R.M.; O’Donnell, K.; Mccormick, S.; Turkington, T.K.; Tekauz, A.; Gilbert, J.; Kistler, H.C.; Busman, M.; Ward, T.J. Diversity of Fusarium head blight populations and trichothecene toxin types reveals regional differences in pathogen composition and temporal dynamics. Fungal Genet. Biol. 2015, 82, 22–31. [Google Scholar] [CrossRef]
- Varga, E.; Wiesenberger, G.; Hametner, C.; Ward, T.J.; Adam, G. New tricks of an old enemy: Isolates of Fusarium graminearum produce a type A trichothecene mycotoxin. Environ. Microbiol. 2014, 17, 2588–2600. [Google Scholar] [CrossRef]
- Liang, J.M.; Xayamongkhon, H.; Broz, K.; Dong, Y.; Mccormick, S.P.; Abramova, S.; Ward, T.J.; Ma, Z.H.; Kistler, H.C. Temporal dynamics and population genetic structure of Fusarium graminearum in the upper Midwestern United States. Fungal Genet. Biol. 2014, 73, 83–92. [Google Scholar] [CrossRef] [PubMed]
- Dame, Z.T.; Rahman, M.; Islam, T. Bacilli as sources of agrobiotechnology: Recent advances and future directions. Green Chem. Lett. Rev. 2021, 14, 246–271. [Google Scholar] [CrossRef]
- Zanon, M.S.A.; Cavaglieri, L.R.; Palazzini, J.M.; Chulze, S.N.; Chiotta, S.N. Bacillus velezensis RC218 and emerging biocontrol agents against Fusarium graminearum and Fusarium poae in barley: In vitro, greenhouse and field conditions. Int. J. Food Microbiol. 2024, 413, 110580. [Google Scholar] [CrossRef]
- Xu, S.; Wang, Y.; Hu, J.; Chen, X.; Qiu, Y.; Shi, J.; Wang, G.; Xu, J. Isolation and characterization of Bacillus amyloliquefaciens MQ01, a bifunctional biocontrol bacterium with antagonistic activity against Fusarium graminearum and biodegradation capacity of zearalenone. Food Control 2021, 130, 108259. [Google Scholar] [CrossRef]
- Dimkpa, C.O.; McLean, J.E.; Britt, D.W.; Anderson, A.J. Antifungal activity of ZnO nanoparticles and their interactive effect with a biocontrol bacterium on growth antagonism of the plant pathogen Fusarium graminearum. Biometals 2013, 26, 913–924. [Google Scholar] [CrossRef]
- Adeniji, A.A.; Babalola, O.O. Tackling maize fusariosis: In search of Fusarium graminearum biosuppressors. Arch. Microbiol. 2018, 200, 1239–1255. [Google Scholar] [CrossRef] [PubMed]
- Colombo, E.M.; Kunova, A.; Pizzatti, C.; Saracchi, M.; Cortesi, P.; Pasquali, M. Selection of an Endophytic Streptomyces sp. Strain DEF09 From Wheat Roots as a Biocontrol Agent Against Fusarium graminearum. Front. Microbiol. 2019, 10, 2356. [Google Scholar] [CrossRef]
- Zhang, J.; Chen, J.; Hu, L.; Jia, R.; Ma, Q.; Tang, J.; Wang, Y. Antagonistic action of Streptomyces pratensis S10 on Fusarium graminearum and its complete genome sequence. Environ. Microbiol. 2021, 23, 1925–1940. [Google Scholar] [CrossRef]
- Kim, Y.T.; Monkhung, S.; Lee, Y.S.; Kim, K.Y. Effects of Lysobacter antibioticus HS124, an effective biocontrol agent against Fusarium graminearum, on crown rot disease and growth promotion of wheat. Can. J. Microbiol. 2019, 65, 904–912. [Google Scholar] [CrossRef]
- Odhiambo, B.O.; Xu, G.; Qian, G.; Liu, F. Evidence of an Unidentified Extracellular Heat-Stable Factor Produced by Lysobacter enzymogenes (OH11) that Degrade Fusarium graminearum PH1 Hyphae. Curr. Microbiol. 2017, 74, 437–448. [Google Scholar] [CrossRef]
- Noel, Z.A.; Roze, L.V.; Breunig, M.; Trail, F. Endophytic Fungi as a Promising Biocontrol Agent to Protect Wheat from Fusarium graminearum Head Blight. Plant Dis. 2022, 106, 595–602. [Google Scholar] [CrossRef]
- Sarrocco, S.; Mauro, A.; Battilani, P. Use of Competitive Filamentous Fungi as an Alternative Approach for Mycotoxin Risk Reduction in Staple Cereals: State of Art and Future Perspectives. Toxins 2019, 11, 701. [Google Scholar] [CrossRef]
- Borchers, A.; Pieler, T. Programming pluripotent precursor cells derived from Xenopus embryos to generate specific tissues and organs. Genes 2010, 1, 413–426. [Google Scholar] [CrossRef] [PubMed]
- Yao, X.; Guo, H.; Zhang, K.; Zhao, M.; Ruan, J.; Chen, J. Trichoderma and its role in biological control of plant fungal and nematode disease. Front. Microbiol. 2023, 14, 1160551. [Google Scholar] [CrossRef] [PubMed]
- Zin, N.A.; Badaluddin, N.A. Biological functions of Trichoderma spp. for agriculture applications. Ann. Agric. Sci. 2020, 65, 168–178. [Google Scholar] [CrossRef]
- Mendoza-Mendoza, A.; Zaid, R.; Lawry, R.; Hermosa, R.; Monte, E.; Horwitz, B.A.; Mukherjee, P.K. Molecular dialogues between Trichoderma and roots: Role of the fungal secretome. Fungal Biol. Rev. 2018, 32, 62–85. [Google Scholar] [CrossRef]
- Blauth de Lima, F.; Félix, C.; Osório, N.; Alves, A.; Vitorino, R.; Domingues, P.; da Silva Ribeiro, R.T.; Esteves, A.C. Trichoderma harzianum T1A constitutively secretes proteins involved in the biological control of Guignardia citricarpa. Biol. Control 2017, 106, 99–109. [Google Scholar] [CrossRef]
- Benítez, T.; Rincón, A.M.; Limón, M.C.; Codón, A.C. Biocontrol mechanisms of Trichoderma strains. Int. Microbiol. 2004, 7, 249–260. Available online: https://www.researchgate.net/publication/8065870 (accessed on 7 July 2025).
- Kim, T.G.; Knudsen, G.R. Relationship between the biocontrol fungus Trichoderma harzianum and the phytopathogenic fungus Fusarium solani f.sp. pisi. Appl. Soil Ecol. 2013, 68, 57–60. [Google Scholar] [CrossRef]
- Matarese, F.; Sarrocco, S.; Gruber, S.; Seidl-Seiboth, V.; Vannacci, G. Biocontrol of Fusarium head blight: Interactions between Trichoderma and mycotoxigenic Fusarium. Microbiology 2012, 158 Pt 1, 98–106. [Google Scholar] [CrossRef]
- Modrzewska, M.; Blaszczyk, L.; Stepien, L.; Urbaniak, M.; Waskiewicz, A.; Yoshinari, T.; Bryla, M. Trichoderma versus Fusarium-Inhibition of Pathogen Growth and Mycotoxin Biosynthesis. Molecules 2022, 27, 8146. [Google Scholar] [CrossRef]
- Tian, Y.; Tan, Y.; Yan, Z.; Liao, Y.; Chen, J.; De Boevre, M.; De Saeger, S.; Wu, A. Antagonistic and Detoxification Potentials of Trichoderma Isolates for Control of Zearalenone (ZEN) Producing Fusarium graminearum. Front. Microbiol. 2017, 8, 2710. [Google Scholar] [CrossRef] [PubMed]
- Rahimi Tamandegani, P.; Marik, T.; Zafari, D.; Balázs, D.; Vágvölgyi, C.; Szekeres, A.; Kredics, L. Changes in Peptaibol Production of Trichoderma Species during In Vitro Antagonistic Interactions with Fungal Plant Pathogens. Biomolecules 2020, 10, 730. [Google Scholar] [CrossRef] [PubMed]
- Alvarez-Garcia, S.; Mayo-Prieto, S.; Gutierrez, S.; Casquero, P.A. Self-Inhibitory Activity of Trichoderma Soluble Metabolites and Their Antifungal Effects on Fusarium oxysporum. J. Fungi 2020, 6, 176. [Google Scholar] [CrossRef] [PubMed]
- Dutta, P.; Mahanta, M.; Singh, S.B.; Thakuria, D.; Deb, L.; Kumari, A.; Upamanya, G.K.; Boruah, S.; Dey, U.; Mishra, A.K.; et al. Molecular interaction between plants and Trichoderma species against soil-borne plant pathogens. Front. Plant Sci. 2023, 14, 1145715. [Google Scholar] [CrossRef]
- Martínez-Medina, A.; Pascual, J.A.; Lloret, E.; Roldán, A. Interactions between arbuscular mycorrhizal fungi and Trichoderma harzianum and their effects on Fusarium wilt in melon plants grown in seedling nurseries. J. Sci. Food Agric. 2009, 89, 1843–1850. [Google Scholar] [CrossRef]
- Fanelli, F.; Liuzzi, V.C.; Logrieco, A.F.; Altomare, C. Genomic characterization of Trichoderma atrobrunneum (T. harzianum species complex) ITEM 908: Insight into the genetic endowment of a multi-target biocontrol strain. BMC Genom. 2018, 19, 662. [Google Scholar] [CrossRef]
- Gams, W.; Bissett, J. Trichoderma and Gliocladium; Kubicek, C.P., Harman, G.E., Eds.; CRC Press: London, UK, 1998; Volume 1, pp. 3–34. Available online: http://library.oum.edu.my/oumlib/node/627352 (accessed on 7 July 2025).
- Guo, C.; Fan, L.; Yang, Q.; Ning, M.; Zhang, B.; Ren, X. Characterization and mechanism of simultaneous degradation of aflatoxin B 1 and zearalenone by an edible fungus of Agrocybe cylindracea GC-Ac2. Front. Microbiol. 2024, 15, 1292824. [Google Scholar] [CrossRef]
- Dennis, C.; Webster, J. Antagonistic properties of species groups of Trichoderma: III. Hyphal interactions. Trans. Br. Mycol. Soc. 1971, 57, 363–369. [Google Scholar] [CrossRef]
- Yue, X.; Ren, X.; Fu, J.; Wei, N.; Altomare, C.; Haidukowski, M.; Logrieco, A.F.; Zhang, Q.; Li, P. Characterization and mechanism of aflatoxin degradation by a novel strain of Trichoderma reesei CGMCC3.5218. Front. Microbiol. 2022, 13, 1003039. [Google Scholar] [CrossRef]
- Whipps, J.M. Effect of media on growth and interactions between a range of soil-borne glasshouse pathogens and antagonistic fungi. New Phytol. 1987, 107, 127–142. [Google Scholar] [CrossRef]
- Li, Y.; Sun, R.; Yu, J.; Saravanakumar, K.; Chen, J. Antagonistic and Biocontrol Potential of Trichoderma asperellum ZJSX5003 Against the Maize Stalk Rot Pathogen Fusarium graminearum. Indian J. Microbiol. 2016, 56, 318–327. [Google Scholar] [CrossRef] [PubMed]
- He, A.-L.; Liu, J.; Wang, X.-H.; Zhang, Q.-G.; Song, W.; Chen, J. Soil application of Trichoderma asperellum GDFS1009 granules promotes growth and resistance to Fusarium graminearum in maize. J. Integr. Agric. 2019, 18, 599–606. [Google Scholar] [CrossRef]
- Tian, Y.; Tan, Y.; Liu, N.; Yan, Z.; Liao, Y.; Chen, J.; De Saeger, S.; Yang, H.; Zhang, Q.; Wu, A. Detoxification of Deoxynivalenol via Glycosylation Represents Novel Insights on Antagonistic Activities of Trichoderma when Confronted with Fusarium graminearum. Toxins 2016, 8, 335. [Google Scholar] [CrossRef] [PubMed]
- Xue, A.G.; Guo, W.; Chen, Y.; Siddiqui, I.; Marchand, G.; Liu, J.; Ren, C. Effect of seed treatment with novel strains of Trichoderma spp. on establishment and yield of spring wheat. Crop Prot. 2017, 96, 97–102. [Google Scholar] [CrossRef]
- Jambhulkar, P.P.; Raja, M.; Singh, B.; Katoch, S.; Kumar, S.; Sharma, P. Potential native Trichoderma strains against Fusarium verticillioides causing post flowering stalk rot in winter maize. Crop Prot. 2022, 152, 105838. [Google Scholar] [CrossRef]
- Ren, X.; Brana, M.T.; Haidukowski, M.; Gallo, A.; Zhang, Q.; Logrieco, A.F.; Li, P.; Zhao, S.; Altomare, C. Potential of Trichoderma spp. for Biocontrol of Aflatoxin-Producing Aspergillus flavus. Toxins 2022, 14, 86. [Google Scholar] [CrossRef]
- Stracquadanio, C.; Luz, C.; La Spada, F.; Meca, G.; Cacciola, S.O. Inhibition of Mycotoxigenic Fungi in Different Vegetable Matrices by Extracts of Trichoderma Species. J. Fungi 2021, 7, 445. [Google Scholar] [CrossRef]
- Simpson, D.R.; Weston, G.; Turner, J.A.; Jennings, P.; Nicholson, P. Differential Control of Head Blight Pathogens of Wheat by Fungicides and Consequences for Mycotoxin Contamination of Grain. Eur. J. Plant Pathol. 2001, 107, 421–431. [Google Scholar] [CrossRef]
- Verma, M.; Brar, S.K.; Tyagi, R.D.; Surampalli, R.Y.; Valéro, J.R. Antagonistic fungi, Trichoderma spp.: Panoply of biological control. Biochem. Eng. J. 2007, 37, 1–20. [Google Scholar] [CrossRef]
- Tang, P.; Huang, D.; Zheng, K.-X.; Hu, D.; Dai, P.; Li, C.H.; Qin, S.Y.; Chen, G.D.; Yao, X.S.; Gao, H. Thirteen new peptaibols with antimicrobial activities from Trichoderma sp. Chin. J. Nat. Med. 2023, 21, 868–880. [Google Scholar] [CrossRef]
- Huang, L.; Wei, M.; Li, L.; Li, Q.; Sun, W.; Yu, X.; Wang, F.; Hu, Z.; Chen, C.; Zhu, H.; et al. Polyketides with Anti-Inflammatory Activity from Trichoderma koningiopsis, a Rhizosphere Fungus from the Medicinal Plant Polygonum paleaceum. J. Nat. Prod. 2023, 86, 1643–1653. [Google Scholar] [CrossRef] [PubMed]
- Hu, Z.; Tao, Y.; Tao, X.; Su, Q.; Cai, J.; Qin, C.; Ding, W.; Li, C. Sesquiterpenes with Phytopathogenic Fungi Inhibitory Activities from Fungus Trichoderma virens from Litchi chinensis Sonn. J. Agric. Food Chem. 2019, 67, 10646–10652. [Google Scholar] [CrossRef] [PubMed]
- De Zotti, M.; Sella, L.; Bolzonello, A.; Gabbatore, L.; Peggion, C.; Bortolotto, A.; Elmaghraby, I.; Tundo, S.; Favaron, F. Targeted Amino Acid Substitutions in a Trichoderma Peptaibol Confer Activity against Fungal Plant Pathogens and Protect Host Tissues from Botrytis cinerea Infection. Int. J. Mol. Sci. 2020, 21, 7521. [Google Scholar] [CrossRef]
- Song, Y.P.; Ji, N.Y. Chemistry and biology of marine-derived Trichoderma metabolites. Nat. Prod. Bioprospect. 2024, 14, 14. [Google Scholar] [CrossRef]
- Chen, S.; Pan, L.; Liu, S.; Pan, L.; Li, X.; Wang, B. Recombinant expression and surface display of a zearalenone lactonohydrolase from Trichoderma aggressivum in Escherichia coli. Protein Expr. Purif. 2021, 187, 105933. [Google Scholar] [CrossRef]
- Dini, I.; Alborino, V.; Lanzuise, S.; Lombardi, N.; Marra, R.; Balestrieri, A.; Ritieni, A.; Woo, S.L.; Vinale, F. Trichoderma Enzymes for Degradation of Aflatoxin B1 and Ochratoxin A. Molecules 2022, 27, 3959. [Google Scholar] [CrossRef]
- Ismaiel, A.A.; Mohamed, H.H.; El-Sayed, M.T. Biodegradation of ochratoxin A by endophytic Trichoderma koningii strains. World J. Microbiol. Biotechnol. 2022, 39, 53. [Google Scholar] [CrossRef]
- Gao, X.; Mu, P.; Wen, J.; Sun, Y.; Chen, Q.; Deng, Y. Detoxification of trichothecene mycotoxins by a novel bacterium, Eggerthella sp. DII-9. Food Chem. Toxicol. 2018, 112, 310–319. [Google Scholar] [CrossRef]
- Liu, Y.; Xu, L.; Shi, Z.; Wang, R.; Liu, Y.; Gong, Y.; Tian, Y.; Kang, X.; Sun, X.; Wang, Y. Identification of an Acinetobacter pittii acyltransferase involved in transformation of deoxynivalenol to 3-acetyl-deoxynivalenol by transcriptomic analysis. Ecotoxicol. Environ. Saf. 2023, 263, 115395. [Google Scholar] [CrossRef]
- Tijerino, A.; Hermosa, R.; Cardoza, R.E.; Moraga, J.; Malmierca, M.G.; Aleu, J.; Collado, I.G.; Monte, E.; Gutierrez, S. Overexpression of the Trichoderma brevicompactumtri5 Gene: Effect on the Expression of the Trichodermin Biosynthetic Genes and on Tomato Seedlings. Toxins 2011, 3, 1220–1232. [Google Scholar] [CrossRef] [PubMed]
- Bolanos-Carriel, C.; Wegulo, S.N.; Baenziger, P.S.; Eskridge, K.M.; Funnell-Harris, D.; Mcmaster, N.; Schmale, D.G.; Hallen-Adams, H.E. Tri5gene expression analysis during postharvest storage of wheat grain from field plots treated with a triazole and a strobilurin fungicide. Can. J. Plant Pathol. 2020, 42, 547–559. [Google Scholar] [CrossRef]

Disclaimer/Publisher’s Note: The statements, opinions and data contained in all publications are solely those of the individual author(s) and contributor(s) and not of MDPI and/or the editor(s). MDPI and/or the editor(s) disclaim responsibility for any injury to people or property resulting from any ideas, methods, instructions or products referred to in the content. |
© 2025 by the authors. Licensee MDPI, Basel, Switzerland. This article is an open access article distributed under the terms and conditions of the Creative Commons Attribution (CC BY) license (https://creativecommons.org/licenses/by/4.0/).
Share and Cite
Ren, X.; Fan, L.; Li, G.; Lyagin, I.V.; Zhang, B.; Ning, M.; Yan, M.; Gao, J.; Wang, F.; Guo, C.; et al. Interaction of Trichoderma Species with Fusarium graminearum Growth and Its Trichothecene Biosynthesis as Further Contribution in Selection of Potential Biocontrol Agents. J. Fungi 2025, 11, 521. https://doi.org/10.3390/jof11070521
Ren X, Fan L, Li G, Lyagin IV, Zhang B, Ning M, Yan M, Gao J, Wang F, Guo C, et al. Interaction of Trichoderma Species with Fusarium graminearum Growth and Its Trichothecene Biosynthesis as Further Contribution in Selection of Potential Biocontrol Agents. Journal of Fungi. 2025; 11(7):521. https://doi.org/10.3390/jof11070521
Chicago/Turabian StyleRen, Xianfeng, Lixia Fan, Guidong Li, Ilya V. Lyagin, Bingchun Zhang, Mingxiao Ning, Mengmeng Yan, Jing Gao, Fei Wang, Changying Guo, and et al. 2025. "Interaction of Trichoderma Species with Fusarium graminearum Growth and Its Trichothecene Biosynthesis as Further Contribution in Selection of Potential Biocontrol Agents" Journal of Fungi 11, no. 7: 521. https://doi.org/10.3390/jof11070521
APA StyleRen, X., Fan, L., Li, G., Lyagin, I. V., Zhang, B., Ning, M., Yan, M., Gao, J., Wang, F., Guo, C., & Logrieco, A. F. (2025). Interaction of Trichoderma Species with Fusarium graminearum Growth and Its Trichothecene Biosynthesis as Further Contribution in Selection of Potential Biocontrol Agents. Journal of Fungi, 11(7), 521. https://doi.org/10.3390/jof11070521

